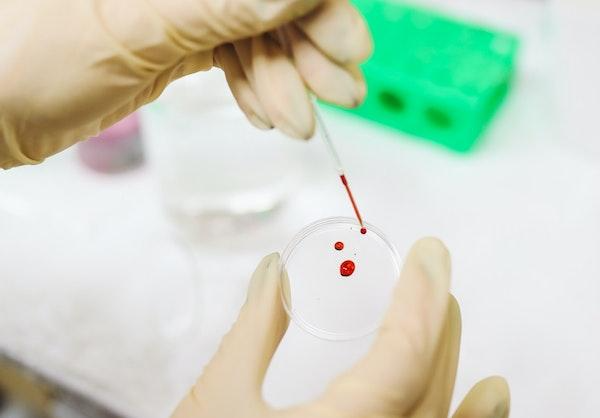

Montana, like several other states, now allows the recreational use of marijuana. Like alcohol, recreational use can lead to overuse, and when combined with driving a motor vehicle, can lead to an arrest for driving under the influence of a drug – marijuana.
DUI or Driving Under the Influence covers absolutely everything from alcohol to illicit drugs and prescription drugs, as well as combinations of all. So – a DUI is not just an alcohol and driving prohibition, it prohibits driving under the influence of drugs as well. But there is a key difference – the training the police need.
Are there sobriety tests for marijuana?
Everyone has seen Standardized Field Sobriety Tests of some kind. Whether it is the finger in front of the eye or the walking on a line test. However, most do not know that all current Standardized Field Sobriety Tests that have been validated by the NHTSA and are required training for all police in the United States are based solely on alcohol results, not drugs. The Standardized Field Sobriety Test battery has no scientific testing or correlation to any drug effects, including marijuana.
What do the cops do if you are under the influence of marijuana?
First, they will continue to run you through the SFSTs for alcohol. Why? Because they haven’t been trained to do anything else. There are some law enforcement officers that have more than standard training and have some experience trying to determine if someone is under the influence of a drug and not alcohol. These officers are known as DREs or Drug Recognition Experts. There are very few DREs in most jurisdictions, and their evaluation doesn’t actually tell what drug someone is under the influence of, nor in what quantity. It’s a guess really.
The only scientific test to determine if someone is under the influence of marijuana is a blood test. Blood can be tested to determine if active THC amounts are in the blood as well as several types of THC metabolites which would indicate prior use and no active THC in the system. People often ask our attorneys if there are any roadside tests to determine marijuana influence, and the short answer is no, there aren’t. Beta programs are being developed to try to measure the accuracy of some portable marijuana testing machines, but to date, none have been approved for use by all law enforcement. Thus, the only way for police to actually prove a Marijuana DUI is through a blood test.
How do the police get your blood for a blood test?
Well, you either voluntarily give it to them – called consent – or they need a search warrant to forcibly withdraw it from you. In Montana, anyone that doesn’t already have a DUI conviction on their record cannot have a search warrant issued to forcibly take their blood. That means, if you don’t voluntarily consent to give it to law enforcement, they can’t get it. If they can’t get it, then there will be no blood test. So, if the police ask you to voluntarily consent to a blood draw for testing purposes, say no! That is your legal right.
In the event you do have a DUI record, law enforcement will likely try to obtain a telephonic search warrant to obtain your blood. These are almost always granted. The officer will then take you to a hospital and have a medical tech use a specific blood test kit to take two vials of your blood. That blood will then be shipped to the crime lab for testing. Those results are used against you.
We are here to help!
Marijuana DUI will become a much more complex crime as use and enforcement evolve. Many, many procedural protocols are required for law enforcement to do all of these things correctly and not violate your rights of privacy. If they don’t follow the protocol correctly, you may be able to get evidence excluded, and that usually results in the case either being dismissed or a non-DUI reduction in charge. The Judnich, Sherwood & Associates has experienced attorneys that are educated and trained in these issues and are here to help you. If you have questions about a marijuana DUI charge in Montana contact us for a free consultation.








